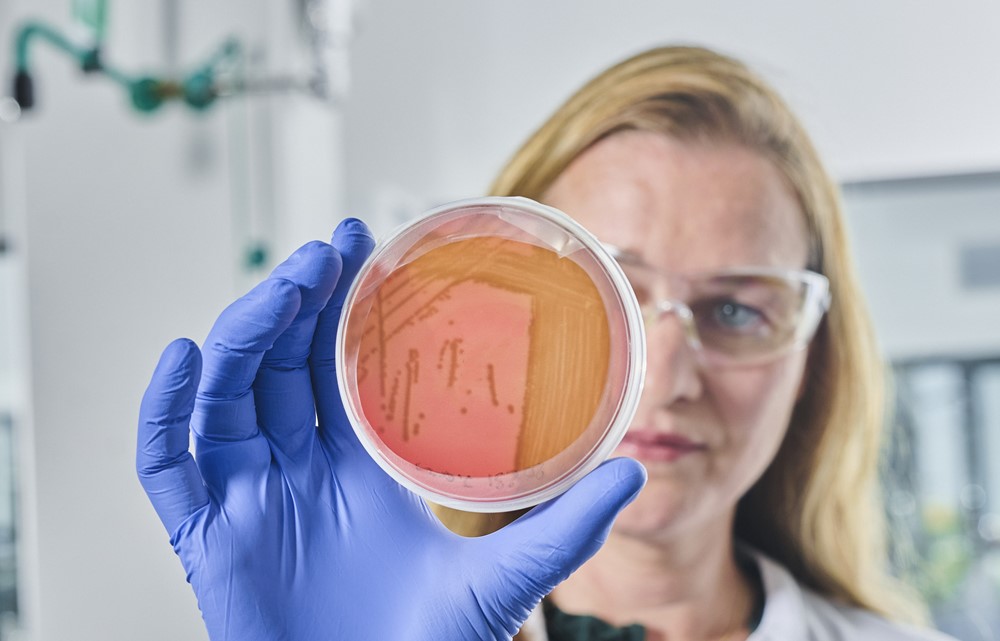
02be81f83fad4f9d8386055bc52d417f-Product_protection_copy.jpg

Open Innovation
Let’s COLLABORATE TO INNOVATE! →Beiersdorf's international success is characterized by strategic collaboration between proven experts in their field. We firmly believe that relevant and transformative innovations emerge at the interfaces where disciplines and expertise meet to go beyond the status quo with new, creative ideas. Hence, we selectively combine external knowledge with our own internal expertise and use this complementary know-how to jointly set new standards in skin care. Our strong global collaboration network includes numerous partners – such as raw material suppliers.
COLLABORATE TO INNOVATE with us!
Innovation is the heartbeat of Beiersdorf. We blend our internal expertise with fresh, external perspectives to redefine the future of skin care. We are inviting you to be an essential part of this journey! Join COLLABORATE TO INNOVATE, our dynamic innovation ecosystem designed to connect brilliant minds like yours with our global Beiersdorf R&D community. Gain insights into our innovation challenges, share your proposals for scouting briefings and showcase your new product launches. At Beiersdorf, we believe in the power of collaboration to transform ideas into meaningful success stories. Let’s COLLABORATE TO INNOVATE!
Our innovation challenges
We aim to create meaningful skincare innovations that that touch people’s lives. In solving our innovation challenges, your collaboration is key! Explore our current topics and submit your ideas. We look forward to COLLABORATE TO INNOVATE with you!

Biodegradable UV filters
Offering effective sun protection while meeting growing consumer and regulatory demands for eco-friendly, reef-safe products.
Submit now
Protection against Oxidation & Degradation
Natural, human- and eco-safe alternatives to prevent oxidation and degradation of cosmetic ingredients and formulas.
Submit now
Biodegradable polymers
Biopolymers that deliver texture, stability, and sensory benefits comparable to traditional polymers while supporting our sustainability goals.
Submit now
Green product protection
Develop eco-friendly, non-sensitizing preservatives that deliver broad-spectrum protection at lower doses—fully compliant with Annex V for safe, sustainable formulations.
Submit now
Sustainable surfactants
Develop eco-optimized surfactants with superior skin compatibility and sensory feel, matching SLES and Cocamidopropyl Betaine in cleansing performance.
Submit now
Share your latest product
Your idea supports us in shaping the future of skin care together, however, it goes beyond our innovation challenges? We are still looking forward to your submission!
Submit nowHow does COLLABORATE TO INNOVATE work?
Our digital innovation ecosystem COLLABORATE TO INNOVATE connects you with the global R&D community of Beiersdorf in a protected environment. Share your ideas proactively or browse our scouting briefings to offer tailored solutions. Currently, our collaboration efforts focus on raw materials. Curious about our requirements? Then check the idea submission link and simply upload your product brochure, specify the raw material class, and add further details if needed. Once submitted, our R&D team will review your idea, and for testing purposes request further documentation to evaluate the portfolio fit early-on. Once testing is complete, expect transparent and aligned feedback. Please be assured that your data will be handled with utmost confidentiality. Ready to COLLABORATE TO INNOVATE with us?
What’s in it for you?
At Beiersdorf, we believe that groundbreaking innovations require external exchange and collaboration. That is why we aim to make the exchange with us as seamless as possible for you. With COLLABORATE TO INNOVATE, you can easily communicate with our entire R&D community, showcase your company profile and product portfolio, share your latest launches, and receive valuable feedback. So, let’s shape the future of skin care together!
Frequently Asked Questions
Why does Beiersdorf use a digital tool to facilitate the exchange on innovations?
At Beiersdorf, we believe that groundbreaking innovations require external exchange and collaboration. That is why we aim to make the exchange with us as seamless as possible for you. With COLLABORATE TO INNOVATE , you can easily communicate with our entire R&D community, showcase your company profile and product portfolio, share your latest launches, and receive valuable feedback. So, let’s shape the future of skin care together!
Will COLLABORATE TO INNOVATE replace in-person exchanges?
COLLABORATE TO INNOVATE is designed to complement, not replace, face-to-face exchanges. It allows you to share your idea across the global Beiersdorf R&D network, receive aligned feedback, and features a chat function for easy communication. Based on the ideas that you share, we will continue to exchange with you personally to deepen discussions.
What kind of ideas are we looking for?
We are very interested in your innovative raw materials delivering an improved performance to enable enhanced product experiences for our consumers.
Please note that, at this stage, COLLABORATE TO INNOVATE focuses exclusively on raw material ideas.
What details does Beiersdorf need to review my ideas?
For an initial review, please provide the product brochure along with the raw material class. Check out the ‘Submit Your Idea’ button to find all details.
What can I expect after submitting an idea?
When you submit an idea, the global Beiersdorf R&D network will have access to it. Our R&D team will review your idea. For testing purposes, we will request further documentation to evaluate the portfolio fit of your product early-on. Once testing is complete, expect transparent and aligned feedback.
Is it possible to sign a Non-Disclosure Agreement before submitting my idea?
Yes, it is. We invite you to join our COLLABORATE TO INNOVATE initiative as a trusted partner. Please click the ‘Join’ button for detailed instructions. The registration process includes signing a NDA to ensure a secure environment for sharing your ideas. Once a NDA is active, you will also gain access to our scouting briefings and more insights. We look forward to welcoming you!
Who evaluates my idea at Beiersdorf?
First, we check whether your product aligns with our portfolio requirements, regarding regulatory, safety and sustainability aspects. This review is done by our Raw Material Innovation team (contact details are available as a platform member). Subsequently, our development labs perform a sample testing, to finally share aligned feedback with you.
How does Beiersdorf handle personal information provided during the registration process on COLLABORATE TO INNOVATE?
Beiersdorf processes your personal data in accordance with the EU General Data Protection Regulation (GDPR). The data you provide during registration (e.g., name, email address) is used to create your account and enable access to collaboration features. Your data is processed securely, transparently, and never sold.
For more details, please refer to our Privacy Policy.
Will all information shared within COLLABORATE TO INNOVATE be treated as confidential?
Yes, Beiersdorf treats all information shared within COLLABORATE TO INNOVATE as confidential and processes it in compliance with applicable data protection laws, including the EU GDPR.For more details, please refer to our Privacy Policy.
© 2026 Beiersdorf - All rights reserved
